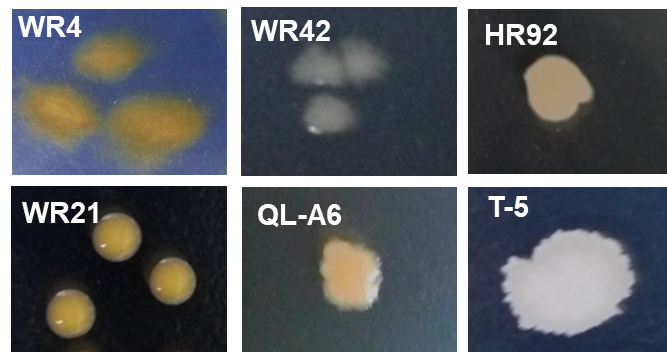

为进一步提高《微生物组实验手册》稿件质量,本项目新增大众评审环节。文章在通过同行评审后,采用公众号推送方式分享全文,任何人均可在线提交修改意见。公众号格式显示略有问题,建议电脑端点击文末阅读原文下载PDF审稿。在线文档(https://kdocs.cn/l/cL8RRqHIL)大众评审页面登记姓名、单位和行号索引的修改建议。修改意见的征集截止时间为推文发布后的72小时,文章将会结合有建设性的修改意见进一步修改后获得DOI在线发表,同时根据贡献程度列为审稿人或致谢。感谢广大同行提出宝贵意见。
为进一步提高《微生物组实验手册》稿件质量,本项目新增大众评审环节。文章在通过同行评审后,采用公众号推送方式分享全文,任何人均可在线提交修改意见。公众号格式显示略有问题,建议电脑端点击文末阅读原文下载PDF审稿。在线文档(https://kdocs.cn/l/cL8RRqHIL)大众评审页面登记姓名、单位和行号索引的修改建议。修改意见的征集截止时间为推文发布后的72小时,文章将会结合有建设性的修改意见进一步修改后获得DOI在线发表,同时根据贡献程度列为审稿人或致谢。感谢广大同行提出宝贵意见。
根际细菌便利和竞争互作类型和强度的研究方法
Determination of Facilitation And Competition Among Rhizobacteria
李梅1, 2,王宏归3,尹悦1,韦中1 *
1江苏省固体有机废弃物资源化高新技术研究重点实验室/江苏省有机固体废弃物资源化协同创新中心/资源节约型肥料教育部工程研究中心/国家有机类肥料工程技术研究中心,资源与环境科学学院,南京农业大学,南京,江苏;2Institute for Environmental Biology, Ecology & Biodiversity, Utrecht University, Padualaan 8, 3584CH Utrecht, The Netherlands;3环境科学与工程学院,扬州大学,扬州,江苏。
*通讯作者邮箱:weizhong@njau.edu.cn
摘要:根际微生物群落结构复杂,群落成员之间有着各种各样的相互作用关系,而且群落结构越复杂,群落成员间的交流也越复杂,这些复杂的相互作用关系会影响到整个群落的功能。在复杂的自然微生物生态系统中,基于高通量数据进行网络互作分析,虽然可以在群落整体水平上理解群落成员间的相互作用关系,但获得具有生物学意义的微生物相互作用关系是非常困难的。本方法通过比较两株菌分别单独培养和共培养后稀释涂布的生长量值来确定两株菌之间的相互作用关系;并根据两株菌之间的互作关系来预测多株菌组成群落 (分别为3株菌、4株菌、5株菌和6株菌) 的互作特征;最后通过使用绝对荧光定量PCR的方法,比较多株菌分别单独培养和共培养后的生长量值来验证多株菌组成群落的互作特征。
关键词:根际细菌,便利关系,竞争关系
材料与试剂
一、试验菌株及质粒
1.WR4 (Flavobacterium johnsoniae) CP000685, WR21 (Chryseobacterium daecheongense) HQ220102, WR42 (Delftia acidovorans) AM180725, HR92 (Lysinibacillus sphaericus) CP000817, T-5 (Bacillus amyloliquefaciens) JF899265 and QL-A6 (Ralstonia pickettii) HQ267096 (Huang et al., 2013; Tan et al., 2013; Wei et al., 2013)
2.大肠杆菌DH5α感受态细胞 (Solarbio, C1100)
3.PMD-19T质粒载体 (pMD19-T Vector takara 6013) :含有用于筛选的氨苄青霉素抗性基因
二、化学试剂
1.葡萄糖 (南京化学试剂有限公司)
2.酵母粉 (OXOID, YEAST EXTRACT, LP0021)
3.牛肉膏 (国药集团化学试剂有限公司,沃凯,69004461)
4.胰蛋白胨 (OXOID, TRYPTONE, LP0042)
5.氯化钠 (NaCl,南京化学试剂有限公司)
6.琼脂 (福建省金燕海洋生物科技股份,乘风)
7.氨苄青霉素
8.Cycle Pure Kit PCR纯化试剂盒 (OMEGA, D6492-01)
9.E.Z.N.A.® Plasmid Mini Kit OMEGA 质粒提取试剂盒 (D6943-01*)
10.细菌DNA提取试剂盒e.Z.N.A (OMEGA bio-tek)
11.荧光定量试剂盒SYBR Premix Ex Taq (TaKaRa BioInc., Japan)
三、培养基
1.液体NA培养基 (见溶液配方)
2.固体NA培养基 (见溶液配方)
3.液体LB培养基 (见溶液配方)
4.固体LB培养基 (见溶液配方)
仪器设备
1.恒温摇床 (MIN QUAN, MQD-BIR)
2.酶标仪 (SpectraMax M5, Sunnyvale, CA, USA)
3.离心机 (Eppendorf AG, 22331 Hamburg, 5424EH062551) 48孔板 (48 well costar clear)
4.-80 °C冰箱 (海尔,立式超低温保存箱,DW-86L626, 2013款)
5.高压灭菌锅 (日本,鸟取,Tega SANYO Industry Co., Ltd, MLS-3780)
6.天平 (sartorius BSA2202S)
7.移液枪 (Eppendorf Research plus)
8.涡旋仪 (SCIENTIFIC INDUSTRIES, USA)
9.恒温恒湿培养箱 (新苗,隔水式电热恒温培养箱,GNP-9080BS-III)
10.一次性培养皿 (江苏康健医疗用品,90 mm)
11.96孔板 (96 well costar clear)
12.48孔板 (48 well costar clear)
13.PCR仪 (life technologies,Applied Biosystems PCR热循环仪)
14.NanoDrop 1000 spectrophotometer (Thermo Scientific, Waltham, MA)
15.荧光定量仪器 Applied Biosystems StepOne Plus (Applied Biosystems, CA, USA)
软件和数据库
1.Excel 2016
2.SigmaPlot 12.5
3.SPSS v. 19
4.Adobe Illustrator CS5
5.DNAMAN 6.0
6.Primer Premier 6.0
实验步骤
一、菌株两两之间互作关系的测定
1.从-80 °C冰箱中取出甘油管保存的6株菌 (WR4, WR21, WR42, T-5, HR92, QL-A6) ,分别于固体NA培养基上划线,30 °C培养48 h。
2.挑取各单菌落分别于NA液体培养基中,在30 °C,170 rpm摇床里培养12 h制备各菌菌悬液,并将各菌株的悬浮液稀释至每毫升约107个菌体 (表1) 。
表1. 各菌株约107个菌体/ml的悬浮液对应的的OD600值
菌株 | OD600 |
WR4 | 0.6 |
WR21 | 0.4 |
WR42 | 0.4 |
T-5 | 0.6 |
HR92 | 0.5 |
QL-A6 | 0.5 |
3.对于菌株单独培养实验,直接将7 μl以上菌悬液加入到含有693 μl液体NA培养基的48孔板中;对于两株菌共培养实验,先将以上菌悬液两两等体积混合均匀,然后再将混合后的7 μl菌悬液加入到含有693 μl液体NA培养基的48孔板中。
4.将以上孔板于170 rpm、30 °C的摇床中培养48 h,然后将各个处理分别在NA固体培养基上进行稀释涂布,对各菌进行计数。6株菌在NA固体培养基上的菌落形态不同 (图1) ,2株菌共培养时可相互区分。这里用i和j分别表示两个菌株,那么单独培养时各自的生物量分别记作MPi和MPj,共培养时共同生物量记作CPi+j,菌株各自的生物量分别记作CPi和CPj。
图1. 六株菌在NA固体培养基上的菌落形态
5.菌株i和菌株j之间的相互作用类型 (便利,中立和竞争) 通过比较菌株单独培养时的生物量之和与共培养时共同生物量之间的关系 (Foster & Bell 2012) 来确定。当MPi + MPj > CPi+j时,二者之间是竞争关系;当MPi + MPj = CPi+j时,二者之间是中立关系;当MPi + MPj < CPi+j时,二者之间是便利关系 (图2) 。

图2. 两菌株间的互作类型确定方法
6.比较两株菌相互作用的方向性:当log10 (CPi/MPi) > 0时,表示菌株j促进菌株i的生长;当log10 (CPi/MPi) < 0时,表示菌株j抑制菌株i的生长;当log10 (CPi/MPi) = 0时,表示菌株j对菌株i的生长没有作用。我们还用以下公式计算了两株菌之间的平均相互作用强度 (MIF) :
 。
。
当MIF > 0时,表示两株菌之间是便利关系;当MIF < 0时,表示两株菌之间是竞争关系;当MIF = 0时,表示两株菌之间是中立关系。
二、基于两株菌之间互作关系来预测多株菌群落 (3株菌、4株菌、5株菌、6株菌) 互作特征
我们用以下公式来预测多株菌群落中菌株之间的平均相互作用强度 (PIF) :
 。
。
其中MIFij表示多株菌组成群落所包含的任一两株菌之间的平均相互作用强度,n表示组成群落的细菌数量,由n株菌组成的群落包含有C2n个MIFij。例如,一个由3株菌组成的群落包含3个MIFij,把这3个MIFij相加再除以3即为此3株菌群落中菌株之间的平均相互作用强度。PIF由小变大则表示群落中菌株间便利关系越来越强,相反,群落中菌株间竞争关系则越来越弱。
三、多株菌组成群落 (3株菌、4株菌、5株菌、6株菌) 中菌株之间平均互作强度 (OIF) 测定
1.从-80 °C冰箱中取出甘油管保存的6株菌 (WR4, WR21, WR42, T-5, HR92, QL-A6) ,于固体NA培养基上划线,30 °C培养48 h。
2.挑取各单菌落分别于NA液体培养基中30 °C,170 rpm摇床里培养12 h制备各菌悬液,并将各菌株的悬浮液稀释至每毫升约107个菌体 (表1) 。
3.对于菌株单独培养实验,直接将7 μl以上菌悬液加入到含有693 μl液体NA培养基的48孔板中;对于多株菌共培养实验,先将以上菌悬液按照共培养中包含的每个菌株等体积混合均匀,然后再将混合后的7 μl菌悬液加入到含有693 μl液体NA培养基的48孔板中。
4.将以上孔板于170 rpm 30 °C的摇床中培养48 h,然后将各个处理用细菌DNA提取试剂盒e.Z.N.A,按照其说明书分别提取DNA,并用NanoDrop 1000 spectrophotometer检测所提取的DNA浓度。将DNA浓度较高的样品进行稀释后备用。
5.六株细菌相互区分的特异性引物设计
5.1 利用DNAMAN 6.0对六株细菌的16S DNA全长序列进行比对分析,找出同源性差别较大的区域,并利用Primer Premier 6.0对该区域设计区分六株细菌的特异性引物 (表2)。
表2. 六株细菌相互区分的特异性引物
菌株 | 正向引物(5' - 3') | 反向引物(5' - 3') |
WR4 | CACTCCTATGTATAGGAGCTTGACG | AGTATCAATGGCCGTTCCAC |
WR21 | CGTTTTTGGGTTTTCGGAT | TGGTAAGGTTCCTCGCGTAT |
WR42 | GAAGTTTCCAGAGATGGATTCG | CCACCTATAAGGGCCATGAG |
T-5 | ACAAGTGCCGTTCAAATAGGG | GCCACTGGTGTTCCTCCAC |
HR92 | GACATCCCGTTGACCACTG | ATTAGCTCCCTCTCGCGAG |
QL-A6 | CTCGAAAGAGAAAGTGGACACAG | GCTTGGCAACCCTCTGTATG |
5.2 引物的特异性验证:(1) 将活化后的六株细菌分别接种于NA培养基中,30 °C、170 r/min振荡培养12 h,以制得的新鲜菌悬液为模版,利用表2中每一对引物对6株细菌都分别在PCR仪 (life technologies,Applied Biosystems PCR热循环仪) 内进行PCR扩增。PCR反应 (50 μl) 包含2 μl细菌菌液,25 μl混合物,各2 μl正向和反向引物,以及19 μl去离子水。PCR反应程序如下:首先在95 °C预热5 min,后进入循环,94 °C变性30 s,60 °C退火30 s,72 °C延伸1 min 30 s,共30个循环。最后在72 °C下延伸10分钟。(2)对PCR产物进行凝胶电泳,确定每一对特异性引物只能扩增出对应菌株的目的片段。
6.定量PCR标准曲线的制定
6.1 将活化后的六株细菌分别接种于NA培养基中,30 °C、170 r/min振荡培养12 h,以制得的新鲜菌悬液为模版,利用各菌株的特异性引物 (表2) 在PCR仪 (life technologies,Applied Biosystems PCR热循环仪) 内对对应菌株进行PCR扩增。PCR反应 (50 μl) 包含2 μl细菌菌液,25 μl混合物,各2 μl正向和反向引物,以及19 μl去离子水。PCR反应程序如下:首先95 °C预热5 min,后进入循环,94 °C变性30 s,60 °C退火30 s,72 °C延伸1 min 30 s,共30个循环。最后72 °C延伸10分钟。
6.2 使用其中2 μl PCR产物进行凝胶电泳,确定扩增出目的片段后,对剩余的48 μl PCR产物使用Cycle Pure Kit PCR纯化试剂盒进行纯化。得到各个引物扩增对应菌株的纯化PCR产物片段。
6.3 通过酶联反应将纯化后的PCR产物片段连接到PMD-19T质粒载体上面,随后通过热激转化将连接成功的质粒转入大肠杆菌感受态DH5α中,涂布于含氨苄抗性 (终浓度100 µg/ml) 的LB平板上,37 °C培养15 h。
6.4 分别挑取在抗性平板上长出来的单菌落 (已成功转入各个菌株特异性片段) 接种于含氨苄抗性 (终浓度100 µg/ml) 的液体LB培养基中,37 °C、170 r/min 振荡培养12 h。然后按照OMEGA 质粒提取试剂盒说明书提取质粒。
6.5 使用Nanodrop测定所得线性质粒的浓度和纯度。代入公式:拷贝数 (copies/μl) =6.02×1023 (copies/mol) ×质粒浓度 (ng/μL) ×10-9/[ (载体质粒分子量+插入特异性片段分子量) ×660] (g/mol) ,计算得到质粒拷贝数。
6.6 将以上计算过拷贝数的质粒进行梯度稀释,得到6个浓度的质粒。将每个浓度的质粒分别作为模版进行荧光定量PCR反应。荧光定量PCR使用荧光定量仪器Applied Biosystems StepOne Plus进行。PCR反应 (20 μl) 包含2 μl质粒,10 μl SYBR Premix Ex Taq,各0.8 μl正向引物和反向引物,0.4 μl Dye I和6 μl无菌去离子水。PCR反应程序为:第一步,95 °C 30 s;第二步,95 °C 5 s, 60 °C 34 s, 40个循环;第三步,95 °C 15 s, 60 °C 1 min, 95 °C 15 s,反应结束后确认扩增曲线和融解曲线。得到每个质粒浓度 (拷贝数) 对应的CT值。以拷贝数的对数值为横坐标,CT为纵坐标绘制标准曲线 (图4) 。

图3. 六株菌分别对应的特异性引物定量PCR标准曲线
7.对步骤4提取的DNA样品中所含的每个菌i使用特异性引物 (表2) 进行荧光定量PCR,以确定处理中每个菌的生物量。菌株i单独培养时的生物量用MPi表示,和其他菌株共培养时的生物量用CPi表示。PCR反应 (20 μl) 包含2 μl细菌DNA,10 μl SYBR Premix Ex Taq,各0.8 μl正向引物和反向引物,0.4 μl Dye I和6 μl无菌去离子水。PCR反应程序为:第一步,95 °C 30 s;第二步,95 °C 5 s, 60 °C 34 s, 40个循环;第三步, 95 °C 15 s, 60 °C 1 min, 95 °C 15 s,反应结束后确认扩增曲线和融解曲线。得到每个菌对应的CT值,然后根据每个菌对应的定量PCR标准曲线 (图3) 计算出每个菌的拷贝数量。
8.多株菌群落中菌株之间的平均相互作用强度 (OIF) 使用以下公式来计算:
 。
。
其中n表示组成群落的细菌数量。当OIF由小变大的过程表示群落中便利关系越来越强,相对的,群落中竞争关系越来越弱。我们发现根据两株菌互作关系预测的多株菌群落平均互作强度 (PIF) 和实际检测到的多株菌群落平均互作强度 (OIF) 之间存在一定的正相关关系 (图5) ,说明两株菌群落中的相互作用在一定程度上可以用来预测多株菌群落中相互作用特征。

图4. 多株菌群落内部平均互作强度预测值 (PIF) 与实测值 (OIF) 间的关系
结果与分析
采用T检验 (SPSS v. 19) 对两株菌单独培养生物量之和与共培养总生物量进行比较,以确定两株菌之间的互作关系。线性相关分析采用 Sigmaplot (v. 12.5) 进行拟合。
溶液配方
1.液体NA培养基
葡萄糖10 g,蛋白胨5 g,酵母粉0.5 g,牛肉膏3 g,1,000毫升去离子水,pH 7.0, 115 °C高压灭菌30 min
2.固体NA培养基
在1,000毫升液体NA培养基的基础上加20 g琼脂,115 °C高压灭菌30 min。
3.液体LB培养基
蛋白胨10 g、酵母粉5 g、NaCl 10 g、去离子水1,000 ml,pH 7.0, 121 °C高压灭菌20 min
4.固体LB培养基
在1,000毫升液体LB培养基的基础上加20 g琼脂,然后121 °C高压灭菌20 min
致谢
本研究由国家自然科学基金 (41471213, 41671248) ,江苏省自然科学基金 (BK20170085) ,青年精英科学家资助计划 (2015QNRC001) 资助,依托于南京农业大学资源与环境科学学院微生态与根际健康实验室 (LorMe) 顺利完成这项实验。
本实验流程基于已发表的论文 (Li et al., 2019) 撰写。
参考文献
1.Foster, K.R. & Bell, T. (2012). Competition, not cooperation, dominates interactions among culturable microbial species. Current biology, 22, 1845-1850.
2.Huang, J., Wei, Z., Tan, S., Mei, X., Yin, S., Shen, Q. et al. (2013). The rhizosphere soil of diseased tomato plants as a source for novel microorganisms to control bacterial wilt. Applied Soil Ecology, 72, 79-84.
3.Li, M., Wei, Z., Wang, J., Jousset, A., Friman, V.P., Xu, Y. et al. (2019). Facilitation promotes invasions in plant-associated microbial communities. Ecology letters, 22, 149-158.
4.Tan, S., Dong, Y., Liao, H., Huang, J., Song, S., Xu, Y. et al. (2013). Antagonistic bacterium Bacillus amyloliquefaciensinduces resistance and controls the bacterial wilt of tomato. Pest Management Science, 69, 1245-1252.
5.Wei, Z., Huang, J., Tan, S., Mei, X., Shen, Q. & Xu, Y. (2013). The congeneric strain Ralstonia pickettii QL-A6 of Ralstonia solanacearum as an effective biocontrol agent for bacterial wilt of tomato. Biological Control, 65, 278-285.
猜你喜欢
10000+:菌群分析 宝宝与猫狗 梅毒狂想曲 提DNA发Nature Cell专刊 肠道指挥大脑
文献阅读 热心肠 SemanticScholar Geenmedical
16S功能预测 PICRUSt FAPROTAX Bugbase Tax4Fun
生物科普: 肠道细菌 人体上的生命 生命大跃进 细胞暗战 人体奥秘
写在后面
为鼓励读者交流、快速解决科研困难,我们建立了“宏基因组”专业讨论群,目前己有国内外5000+ 一线科研人员加入。参与讨论,获得专业解答,欢迎分享此文至朋友圈,并扫码加主编好友带你入群,务必备注“姓名-单位-研究方向-职称/年级”。PI请明示身份,另有海内外微生物相关PI群供大佬合作交流。技术问题寻求帮助,首先阅读《如何优雅的提问》学习解决问题思路,仍未解决群内讨论,问题不私聊,帮助同行。

学习16S扩增子、宏基因组科研思路和分析实战,关注“宏基因组”
 点击阅读原文下载PDF审稿,或浏览器直接访问下载链接:http://210.75.224.110/github/MicrobiomeProtocol/04Review/210118/2003713ZhongWei952682/Protocol2003713revised.pdf
点击阅读原文下载PDF审稿,或浏览器直接访问下载链接:http://210.75.224.110/github/MicrobiomeProtocol/04Review/210118/2003713ZhongWei952682/Protocol2003713revised.pdf




 本文介绍了一种确定根际细菌便利和竞争互作类型及强度的方法,通过比较两株菌单独培养和共培养后的生长量值来确定它们之间的相互作用关系,并预测多株菌组成群落的互作特征。
本文介绍了一种确定根际细菌便利和竞争互作类型及强度的方法,通过比较两株菌单独培养和共培养后的生长量值来确定它们之间的相互作用关系,并预测多株菌组成群落的互作特征。
















 4051
4051

 被折叠的 条评论
为什么被折叠?
被折叠的 条评论
为什么被折叠?








